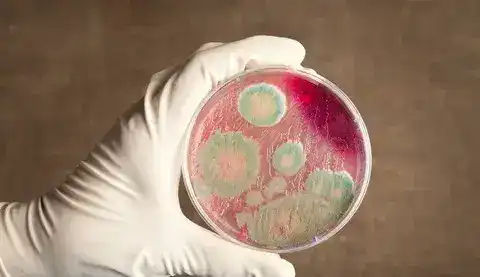
Байсерк: сибирская язва не угрожает жителям

В Алматинской области, в селе Байсерке, находится захоронение сибирской язвы, идентифицированное как В/04/00061. Оно расположено на земельном участке частной собственности, принадлежащем ТОО "Транспетролеум". По архивным данным, в 1958 году там было захоронено одно крупное рогатое животное, а в 1968 году — две лошади. Вокруг этого захоронения установлена санитарно-защитная зона радиусом 1000 метров, которая охватывает часть территории Байсерке и прилегающие земельные участки соседнего села Киши Байсерке Талгарского района.
Создание рабочей группы
Согласно информации местных властей, в настоящее время для населения угрозы нет. Для всестороннего изучения ситуации и определения необходимых мер, акимом Илийского района было создано распоряжение, согласно которому сформирована рабочая группа. Ее возглавляет заместитель акима района, а в состав группы вошли представители различных ведомств, включая ветеринарную инспекцию и санитарно-эпидемиологический контроль, а также научные консультанты из ТОО "Казахский научно-исследовательский ветеринарный институт".
Исследовательская работа и меры безопасности
Рабочая группа уже провела два заседания, на которых были подготовлены предложения по уточнению местоположения захоронения, а также корректировке санитарно-защитной зоны. В данный момент осуществляется анализ архивных документов и собранных данных. Окончательные решения относительно захоронения и необходимых мер безопасности будут приняты в течение месяца на итоговом заседании рабочей группы.
Кроме того, в распоряжение акима Илийского района от 8 апреля 2016 года о местах захоронений сибирской язвы будут внесены соответствующие изменения на основании результатов работы группы.